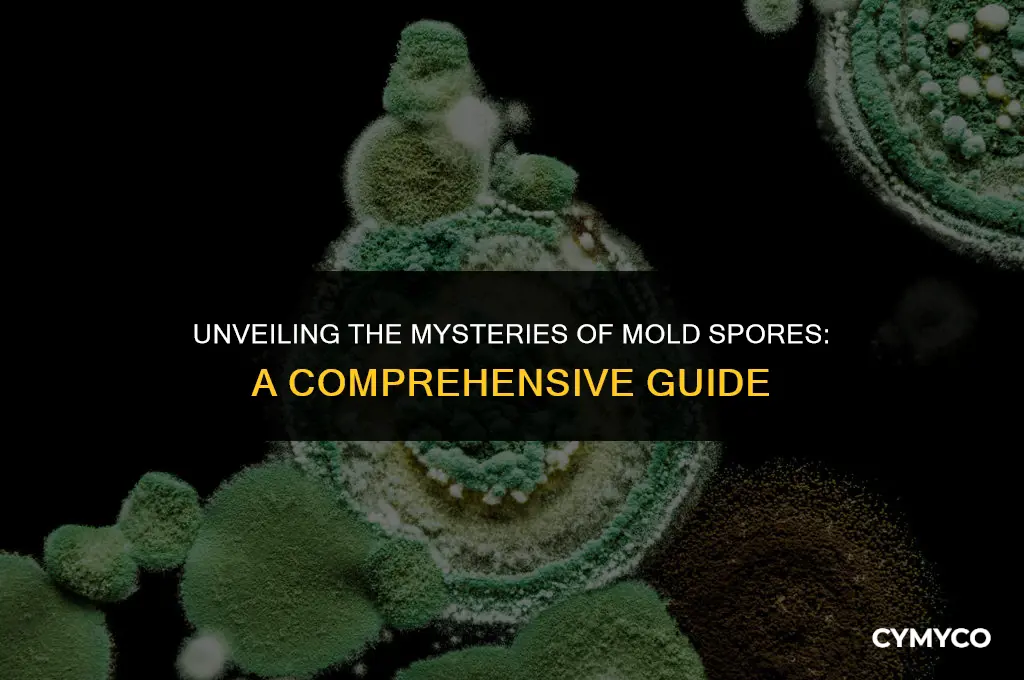
what is mold spores

Mold spores are microscopic reproductive structures produced by fungi, commonly known as molds. These spores are crucial for the mold's life cycle, allowing it to spread and colonize new environments. Mold spores are typically released into the air and can travel long distances, often settling on surfaces where they can germinate and grow into new mold colonies. Understanding mold spores is essential for preventing mold growth in homes and buildings, as well as for addressing potential health risks associated with mold exposure.
| Characteristics | Values |
|---|---|
| Definition | Mold spores are microscopic reproductive structures produced by molds, a type of fungus. They are released into the environment to propagate and grow into new mold colonies. |
| Size | Mold spores are typically very small, ranging from 1 to 100 micrometers in diameter. |
| Shape | The shape of mold spores varies depending on the species. Common shapes include round, oval, cylindrical, and multicellular structures. |
| Color | Mold spores can be colorless or have a variety of colors, including green, black, white, and brown. |
| Production | Mold spores are produced in large quantities, especially in environments with high humidity and organic matter. |
| Dispersal | Mold spores are dispersed through the air, water, or by sticking to surfaces and objects. |
| Viability | Mold spores can remain viable for long periods, sometimes years, until they find suitable conditions to germinate and grow. |
| Allergenicity | Many mold spores are allergenic and can cause respiratory problems and allergic reactions in sensitive individuals. |
| Toxicity | Some mold spores produce mycotoxins, which can be toxic to humans and animals if ingested, inhaled, or absorbed through the skin. |
| Identification | Mold spores can be identified using microscopic examination, culture techniques, or DNA analysis. |
| Prevention | To prevent mold spore production and dispersal, it is important to control moisture levels, clean and disinfect surfaces regularly, and use mold-resistant materials in construction and renovation. |
| Remediation | If mold spores are present, remediation efforts may include cleaning and disinfecting surfaces, removing contaminated materials, and improving ventilation and air quality. |
Explore related products
$13.48 $14.13
What You'll Learn
- Definition: Mold spores are microscopic reproductive units produced by fungi to spread and grow
- Structure: Typically, mold spores are small, round or oval-shaped, and have a hard outer shell for protection
- Dispersal: Mold spores are released into the air and can travel long distances, settling on surfaces to germinate
- Health Effects: Inhaling mold spores can cause allergic reactions, respiratory issues, and other health problems in humans
- Prevention: Controlling moisture, improving ventilation, and cleaning regularly can help prevent mold spore growth and dispersal

Definition: Mold spores are microscopic reproductive units produced by fungi to spread and grow
Mold spores are a critical component in the life cycle of fungi, serving as the primary means of reproduction and dispersal. These microscopic units are incredibly resilient and can survive in a variety of environmental conditions, including extreme temperatures, high levels of radiation, and even the vacuum of space. This durability allows mold spores to spread over vast distances and colonize new environments, making them a ubiquitous presence in our world.
The process of mold spore production begins with the growth of a mature fungus, which can take the form of a multicellular organism known as a mycelium. The mycelium produces specialized structures called sporophores, which are responsible for generating and releasing spores into the environment. Depending on the species of fungus, spores can be produced through various mechanisms, such as asexual reproduction via mitosis or sexual reproduction through the fusion of gametes.
Once released, mold spores can travel through the air, water, or soil, eventually landing on a suitable substrate where they can germinate and grow into a new fungal colony. This process is facilitated by the presence of specific nutrients and environmental conditions, such as moisture, warmth, and organic matter. As the new colony grows, it will continue the cycle by producing its own spores, ensuring the ongoing propagation of the fungal species.
The ubiquity and resilience of mold spores have significant implications for human health and the environment. While many species of fungi are harmless or even beneficial, some can cause serious health problems, particularly in individuals with compromised immune systems. Additionally, the ability of mold spores to survive in extreme conditions makes them a potential concern for the spread of fungal diseases and the contamination of food and water supplies.
Understanding the nature and behavior of mold spores is essential for developing effective strategies to control and prevent the spread of harmful fungi. This knowledge can inform the development of new antifungal treatments, as well as public health initiatives aimed at reducing the incidence of fungal infections. Furthermore, studying the mechanisms of mold spore production and dispersal can provide valuable insights into the ecology and evolution of fungi, contributing to our broader understanding of the natural world.
Unveiling the Microscopic World: The Size of Mold Spores Explained
You may want to see also
Explore related products

Structure: Typically, mold spores are small, round or oval-shaped, and have a hard outer shell for protection
Mold spores are incredibly small, often measuring only a few micrometers in diameter. This minute size allows them to float effortlessly through the air, spreading to new locations and surfaces. Despite their small size, mold spores are remarkably resilient, thanks in part to their hard outer shell. This protective layer, known as the spore wall, is composed of a tough, cellulose-like material that shields the delicate genetic material inside from environmental hazards such as UV radiation, extreme temperatures, and desiccation.
The shape of mold spores can vary, but they are typically round or oval. This streamlined form helps them to disperse more efficiently through the air, carried by even the slightest breeze or air current. Some mold spores may also have specialized structures, such as wings or appendages, that aid in their dispersal. For example, the spores of some Aspergillus species have a distinctive, star-shaped appendage that helps them to catch the wind and travel farther.
One of the key functions of the spore wall is to protect the mold spore during its journey through the environment. The wall acts as a barrier against physical damage and helps to prevent the spore from drying out. It also contains proteins and other molecules that can help the spore to adhere to surfaces, increasing the chances of successful germination and growth. When conditions are right, such as when the spore lands on a suitable substrate with adequate moisture and nutrients, the spore wall will rupture, allowing the genetic material inside to begin the process of germination and growth into a new mold colony.
Understanding the structure of mold spores is crucial for developing effective strategies for mold prevention and remediation. By knowing how mold spores are dispersed and how they protect themselves, we can better design ventilation systems, cleaning protocols, and other measures to reduce the risk of mold growth in indoor environments. For example, using HEPA filters in vacuum cleaners can help to capture mold spores, preventing them from being spread throughout a building. Similarly, maintaining proper humidity levels and promptly addressing water damage can help to reduce the likelihood of mold spore germination and growth.
Decoding the Meaning of 'Spor': A Comprehensive Guide
You may want to see also
Explore related products

Dispersal: Mold spores are released into the air and can travel long distances, settling on surfaces to germinate
Mold spores are microscopic reproductive units produced by fungi, designed for dispersal and survival. Their release into the air is a crucial part of the mold life cycle, allowing them to travel long distances and colonize new areas. This dispersal mechanism is highly effective, enabling mold spores to settle on various surfaces where they can germinate and grow under suitable conditions.
The process of spore dispersal is influenced by several factors, including environmental conditions, the type of mold, and the availability of nutrients. Mold spores can be carried by air currents, water droplets, or even animals and insects, facilitating their widespread distribution. Once they land on a surface, spores can remain dormant for extended periods, waiting for the right combination of moisture, temperature, and nutrients to initiate germination.
Understanding the dispersal of mold spores is essential for preventing mold growth in indoor environments. By controlling factors such as humidity, ventilation, and cleanliness, it is possible to reduce the likelihood of spore germination and subsequent mold colonization. Regular cleaning and maintenance of surfaces prone to mold growth, such as bathrooms and kitchens, can also help to minimize the presence of mold spores.
In addition to their role in mold reproduction, spores can also have significant health implications for humans. Inhaling mold spores can trigger allergic reactions, respiratory issues, and other health problems, particularly in individuals with compromised immune systems or pre-existing conditions. Therefore, it is crucial to take steps to limit exposure to mold spores and to address any mold growth promptly.
Overall, the dispersal of mold spores is a complex and highly effective process that plays a vital role in the propagation of mold. By understanding the factors that influence spore dispersal and taking proactive measures to control mold growth, it is possible to mitigate the health risks associated with mold exposure and maintain a safe and healthy indoor environment.
Lysol's Effectiveness Against Ringworm Spores: A Comprehensive Guide
You may want to see also
Explore related products

Health Effects: Inhaling mold spores can cause allergic reactions, respiratory issues, and other health problems in humans
Inhaling mold spores can have significant health implications, particularly for individuals with pre-existing respiratory conditions or allergies. When mold spores are inhaled, they can trigger allergic reactions, leading to symptoms such as sneezing, itching, and watery eyes. In more severe cases, prolonged exposure to mold spores can result in chronic respiratory issues, including asthma exacerbation and the development of respiratory infections.
The health effects of mold spores are not limited to respiratory issues. In some cases, inhalation of mold spores can lead to more systemic health problems, such as headaches, fatigue, and even neurological symptoms. Individuals with compromised immune systems, such as those undergoing chemotherapy or living with HIV/AIDS, are particularly susceptible to the health effects of mold spores and may experience more severe symptoms.
It is important to note that the health effects of mold spores can vary depending on the type of mold and the concentration of spores in the air. Some types of mold, such as black mold (Stachybotrys chartarum), are known to produce mycotoxins that can be harmful if inhaled. In addition, the health effects of mold spores can be exacerbated by factors such as poor ventilation, high humidity, and the presence of other allergens or irritants in the environment.
To mitigate the health risks associated with mold spores, it is essential to take steps to prevent mold growth in the home and workplace. This can include regular cleaning and maintenance of HVAC systems, prompt repair of water leaks, and the use of mold-resistant paints and materials. In cases where mold growth is suspected, it is important to have the area professionally inspected and remediated to prevent further exposure to mold spores.
In conclusion, the health effects of inhaling mold spores can be significant and far-reaching, particularly for individuals with pre-existing health conditions. By taking steps to prevent mold growth and promptly addressing any suspected mold issues, individuals can reduce their risk of exposure to mold spores and the associated health problems.
Unveiling the Hidden Dangers: Understanding Mold Spores and Their Impact
You may want to see also
Explore related products

Prevention: Controlling moisture, improving ventilation, and cleaning regularly can help prevent mold spore growth and dispersal
Mold spores are a common concern in many households and buildings, but there are effective strategies to prevent their growth and dispersal. One key approach is to control moisture levels, as mold thrives in damp environments. This can be achieved by fixing leaks, using dehumidifiers, and ensuring proper drainage around the building. Improving ventilation is another crucial step, as it helps to circulate air and reduce humidity. This can be done by opening windows, using exhaust fans, and maintaining air conditioning systems.
Regular cleaning is also essential in preventing mold spore growth. This includes wiping down surfaces with a mold-killing solution, vacuuming carpets and upholstery, and washing bedding and clothing in hot water. It's important to focus on areas that are prone to moisture, such as bathrooms, kitchens, and basements. By implementing these preventive measures, individuals can significantly reduce the risk of mold spore growth and dispersal, leading to a healthier living environment.
In addition to these general strategies, there are specific steps that can be taken to address mold spores in different areas of the home. For example, in the bathroom, it's important to clean the shower and bathtub regularly and use a squeegee to remove excess water. In the kitchen, it's crucial to clean up spills immediately and store food in airtight containers. By targeting these specific areas and implementing tailored preventive measures, individuals can further reduce the risk of mold spore growth and dispersal.
Overall, preventing mold spore growth and dispersal requires a comprehensive approach that includes controlling moisture, improving ventilation, and cleaning regularly. By following these strategies and focusing on specific areas of the home, individuals can create a healthier living environment and reduce the risk of mold-related health issues.
Unlocking the Secrets: The Vital Role of Heat in Spore Staining
You may want to see also
Frequently asked questions
Mold spores are tiny, airborne reproductive units produced by molds. They are similar to the seeds of plants and can travel through the air, water, or soil to find a suitable environment for growth.
Mold spores can cause a variety of health issues, particularly for individuals with allergies, asthma, or weakened immune systems. Inhaling mold spores can trigger allergic reactions, respiratory problems, and in some cases, more severe health complications.
Mold spores are ubiquitous in the environment and can be found both indoors and outdoors. They thrive in damp, warm, and humid conditions, often growing on decaying organic matter such as wood, leaves, and food.











































